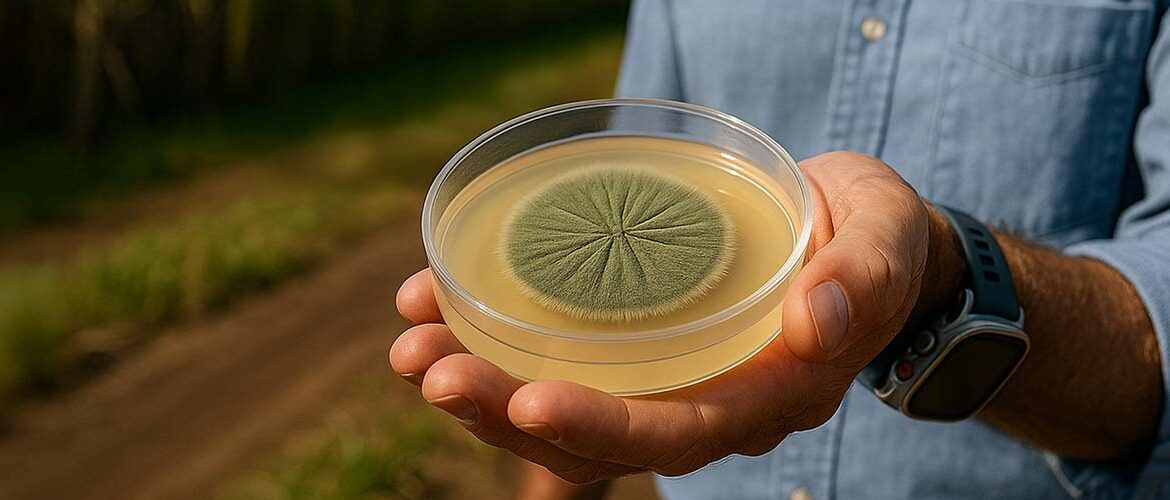
Falta de refrigeração compromete eficiência de bioinsumos no campo, alerta executivo do setor

A Tópico anuncia a implantação de um marco inédito no setor logístico: o maior galpão lonado linear já construído na
A Indumak, empresa voltada a equipamentos de empacotamento, agrupamento e movimentação de produtos para a indústria, sempre atenta às demandas
O Acelerador da Transição Industrial (ITA) e a Mission Possible Partnership (MPP) informaram que a indústria limpa está entrando em
O Brasil vem ampliando a capacidade instalada de energia solar, favorecendo a expansão da tecnologia em áreas urbanas e rurais,
Numa evolução de sua consagrada tecnologia de Aceleração Inteligente, a Volvo lança agora o I-Torque, com benefícios ao desempenho e
*Alessandro Carboni Casado, gerente de projetos e instrutor da EvolutaPro Treinamento A transformação digital está redesenhando o perfil dos profissionais
O Banco Nacional de Desenvolvimento Econômico e Social (BNDES) aprovou operação de R$ 117,2 milhões do Fundo para o Desenvolvimento
A Busch do Brasil, empresa integrante do Busch Group global e especialista em tecnologia de vácuo, anuncia o lançamento do
O uso de bioinsumos no Brasil tem mostrado um crescimento significativo nas últimas décadas, especialmente na safra 2024/2025. O uso
A adoção de drones agrícolas tem transformado a forma como o agronegócio brasileiro gerencia recursos naturais e busca maior sustentabilidade